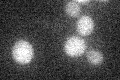
YLL003W
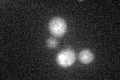
YLL003W

View description
Centrin (Cdc31p)-binding protein required for spindle pole body (SPB) duplication, localizes to the half-bridge of the SPB, required for progression through G(2)-M transition, has similarity to Xenopus laevis XCAP-C
Localization:
Intensity:
Fold change:
Significance:
-
C’ GFP library in SD
below threshold16.04 -
N' NOP1pr-GFP in SD

cytosol,punctate,nucleus37.2094 -
N' TEF2pr-mCherry in SD

nucleus29.1961 -
N' NATIVEpr-GFP in SD

missing0 -
N' TEF2pr-VC and Cyto-VN in SD

#N/A0 -
C’ GFP library in SD+DTT
cytosol15.60.97No -
C’ GFP library in SD+H2O2

cytosol17.111.06No -
C’ GFP library in Starvation Media

cytosol15.520.96No -
C’ GFP library on the background of Pup2-DaMP

below threshold -
C’ GFP library on the background of CCT mutant

below threshold17.20591.07238No
